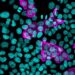
Haberse infectado antes de la primera dosis mejora la respuesta inmunitaria contra la COVID-19

El ministro de la Presidencia, Lisandro Macarrulla, acompañado por el director ejecutivo (DGAPP), Sigmund Freund, agotan una agenda de dos días en esa provincia.
PEDERNALES. El ministro de la Presidencia, Lisandro Macarrulla y el director ejecutivo de la Dirección General de Alianzas Público Privadas (DGAPP), Sigmund Freund, agotan desde este viernes una agenda de dos días en esta provincia, con la finalidad de supervisar los avances del Proyecto de Desarrollo Turístico de Pedernales-Cabo Rojo, que ejecuta el Gobierno en esta zona del país.

La agenda se inició con la participación de ambos funcionarios en el programa especial de radio “Pedernales 64 años después”, del periodista Carlos Julio Feliz, como parte del periplo por el aniversario de la provincia.
El ministro Macarrulla resaltó la importancia que tiene para el presidente Luis Abinader este proyecto de desarrollo turístico en Cabo Rojo-Pedernales, al proclamar que es hora de poner fin a la pobreza que por tantos años ha caracterizado esta provincia y a toda región sur.
Agregó que es una prioridad del Gobierno desarrollar un proyecto que pueda generar riquezas y, a su vez, proteger los activos más importantes que tiene esa provincia: los recursos naturales y su gente.
“Aquí nada se hará sin que se realicen todos los estudios que se requieran, para garantizar la sostenibilidad de este destino, que desde ya promete ser un referente regional”.
Lisandro Macarrulla
De su lado, en su intervención, el director de la DGAPP, Sigmund Freund, explicó en detalle el Máster Plan del proyecto, al puntualizar que este será el destino más planificado que tendrá República Dominicana y un modelo de alianza público-privada único en el Caribe a nivel turístico.
“El destino Cabo Rojo-Pedernales está llamado a cambiar el rostro económico y social de esta región sur, creando verdaderas oportunidades de empleo y de negocios, generando beneficios para los productores locales. Son más de 20,000 empleos directos que estimamos se crearán en los próximos 10 años y más de 50,000 indirectos”, expresó Freund.
Freund indicó que el desarrollo turístico de Pedernales ya no es una promesa como en gestiones pasadas de gobierno, pues ya se notan los avances en la construcción de las vías internas del proyecto, en la construcción de la carretera Enriquillo-Pedernales, en el compromiso de más de seis cadenas hoteleras de fama internacional que iniciarán la construcción de las primeras habitaciones a mediados de este año.
Resaltó, además, la visita y reciente compromiso del presidente del Banco Centroamericano de Integración Económica (BCIE), Dante Mossi, para gestionar el financiamiento internacional que requiere el proyecto.
“Hoy es un día histórico para Pedernales”, resaltó Freund, al señalar que la presencia del ministro de la Presidencia, de autoridades de otras instituciones públicas y locales es una muestra del compromiso que existe para impulsar el desarrollo económico de la provincia mediante un proyecto turístico responsable en alianza público-privada.
Al concluir el programa especial de radio, el ministro Macarrulla y Freund participaron del lanzamiento del proyecto “Fomento de Alianza Público-Privada para el fortalecimiento de la cadena del Turismo Sostenible en Pedernales” financiado por la Agencia Española de Cooperación Internacional para el Desarrollo (AECID).
Este proyecto, liderado por el Viceministerio de Cooperación del Ministerio de Turismo, busca promover el desarrollo sostenible de Pedernales a través del turismo aprovechando el patrimonio local, natural y cultural de la región.
En esta actividad, además del ministro de la Presidencia y el director de la DGAPP, estuvieron presentes el viceministro de Economía, Planificación y Desarrollo, Pavel Isa; el viceministro de Cooperación del Ministerio de Turismo, Carlos Peguero; el embajador de España en el país, Antonio Pérez-Hernández; el alcalde del municipio, Andrés Emilio Jiménez Sánchez, entre otras personalidades.
Más tarde, el ministro Macarrulla y el director de la DGAPP se trasladaron a la Gobernación Provincial, donde la Comisión Presidencial para el Desarrollo Turístico de Pedernales presentó los “Lineamientos para el Plan de Desarrollo Social y Económico para la Provincia de Pedernales y Enriquillo”.
Al finalizar la tarde, ambos funcionarios sostuvieron una reunión con la filial Pedernales de la Asociación Dominicana de Periodistas Turísticos (Adompretur) y luego visitaron los Tres Charcos, lugar donde se estará construyendo el aeropuerto Internacional de Pedernales.
En la agenda para el sábado 2 de abril, el ministro Macarrulla tiene pautado encabezar la graduación de los primeros 1,500 técnicos formados por el Instituto en Formación Técnico Profesional (Infotep) y la Comisión Presidencial para el Desarrollo Turístico de Pedernales, bajo la misión de preparar el capital humano que tendrá a cargo el desarrollo hotelero del destino Cabo Rojo-Pedernales.
Asimismo, visitarán la zona de Cabo Rojo donde se construirán las primeras instalaciones hoteleras incluyendo el muelle, la playa, el hotel del Acantilado y Bahía de las Águilas.
Sobre el proyecto
El Proyecto de Desarrollo Turístico de Pedernales-Cabo Rojo está concebido para realizarse en cuatro fases, durante un período promedio de 10 años y una inversión estimada de US$2,245 millones.
En la primera fase se estipula una inversión de US$1,300 millones para la construcción de 4,700 habitaciones (que se convertirán en 12,000 habitaciones al final del proyecto).
Ocho hoteles iniciarán sus operaciones durante la apertura de esa primera fase, para lo cual ya las cadenas hoteleras Hilton, Marriot, Sunwing, AmResorts, Iberostar Group y Karisma Hotels & Resort han firmado carta de compromiso para empezar la construcción de sus hoteles a partir de mediados de este 2022.
En esta primera fase se construirá también un aeropuerto internacional en Pedernales, un centro comercial y se concluirán las obras de infraestructuras básicas necesarias, como la construcción de un acueducto, una planta de tratamiento de aguas y un sistema de transmisión eléctrica.